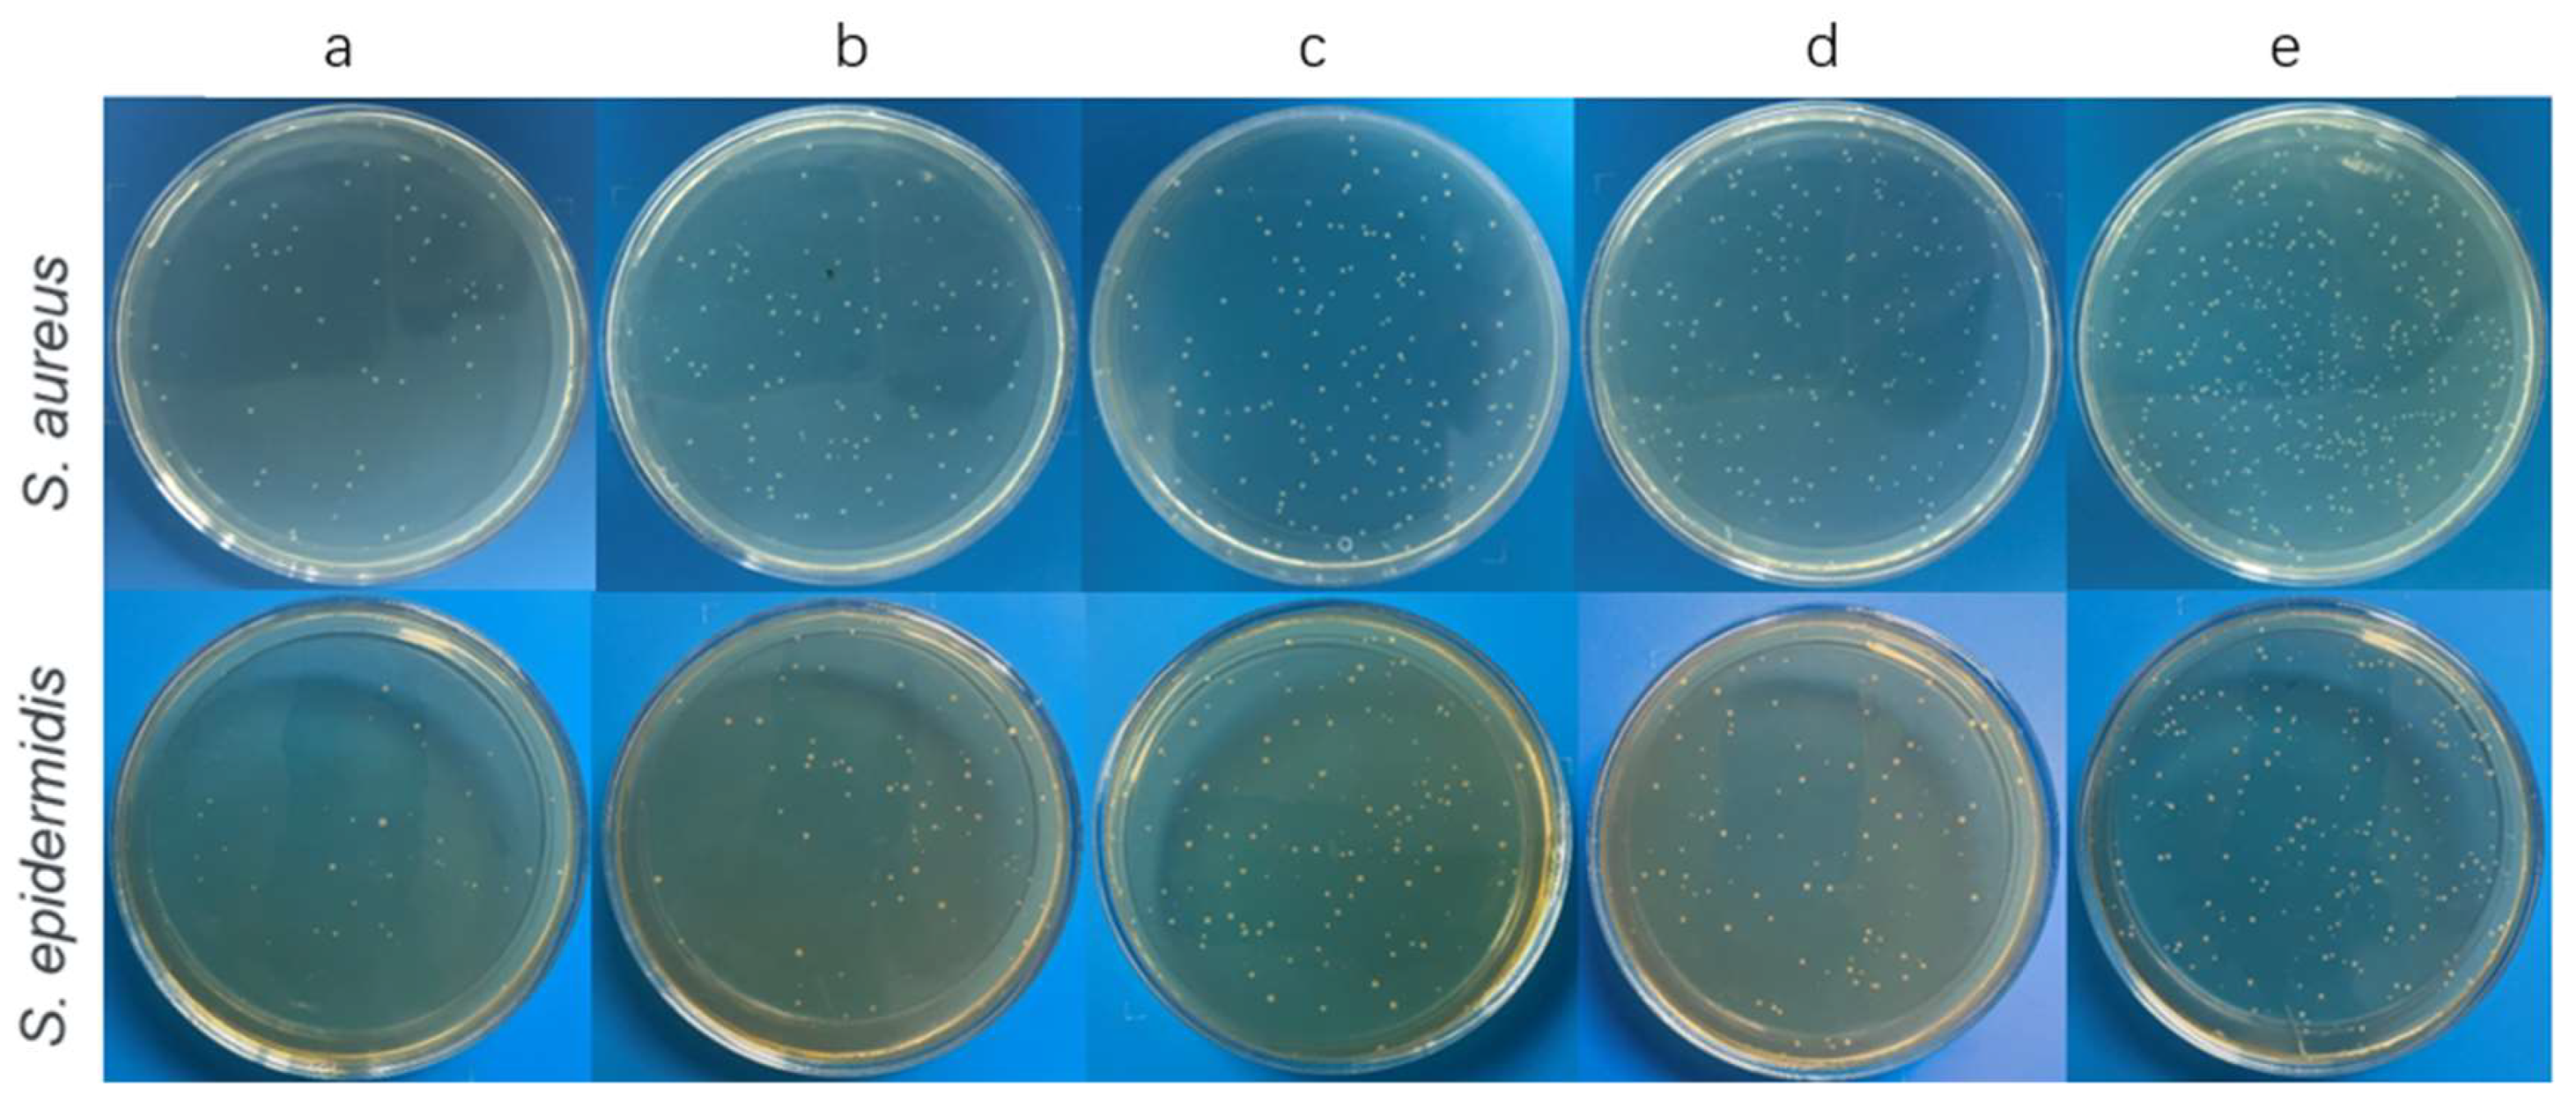
Coatings 12 00414 g004

Surface Modification of Titanium by Femtosecond Laser in Reducing Bacterial Colonization
Abstract
:1. Introduction
2. Materials and Methods
2.1. Bionic Microtopography Coatings Sample Preparation
2.2. Surface Characterization
2.2.1. Surface Morphology Measurements
2.2.2. Chemical Composition Measurements
2.2.3. Wettability Measurements
2.3. Antimicrobial Assays
2.3.1. Bacterial Inhibitory Assays
2.3.2. Confocal Laser Scanning Microscopy (CLSM) Assays
2.3.3. Scanning Electron Microscopy (SEM) Assays
2.4. Cell Assays
2.4.1. Cell Culture
2.4.2. Cell Viability Assays
2.4.3. Adhesion and Proliferation Assays
2.5. Statistical Analysis
3. Results
3.1. Surface Characterization
3.1.1. Surface Morphology
3.1.2. Chemical Composition
3.1.3. Surface Wettability
3.2. Antimicrobial Assays
3.2.1. Bacterial Inhibitory Assays
3.2.2. Confocal Laser Scanning Microscopy (CLSM) Assays
3.2.3. Scanning Electron Microscopy (SEM) Assays
3.3. Cell Assays
3.3.1. Cell Viability Assays
3.3.2. Adhesion and Proliferation Assays
4. Discussion
5. Conclusions
Author Contributions
Funding
Institutional Review Board Statement
Informed Consent Statement
Data Availability Statement
Conflicts of Interest
References
- Kaur, M.; Singh, K. Review on titanium and titanium based alloys as biomaterials for orthopaedic applications. Mater. Sci. Eng. C 2019, 102, 844–862. [Google Scholar] [CrossRef] [PubMed]
- Arciola, C.R.; Campoccia, D.; Montanaro, L. Implant infections: Adhesion, biofilm formation and immune evasion. Nat. Rev. Microbiol. 2018, 16, 397–409. [Google Scholar] [CrossRef] [PubMed]
- Reffuveille, F.; Josse, J.; Vallé, Q.; Gangloff, C.M.; Gangloff, S.C. Staphylococcus aureus Biofilms and their Impact on the Medical Field. Rise Virulence Antibiot. Resist. Staphylococcus Aureus 2017, 11, 187. [Google Scholar]
- Chouirfa, H.; Bouloussa, H.; Migonney, V.; Falentin-Daudré, C. Review of titanium surface modification techniques and coatings for antibacterial applications. Acta Biomater. 2019, 83, 37–54. [Google Scholar] [CrossRef] [PubMed]
- Zhang, X.-F.; Liu, Z.-G.; Shen, W.; Gurunathan, S. Silver Nanoparticles: Synthesis, Characterization, Properties, Applications, and Therapeutic Approaches. Int. J. Mol. Sci. 2016, 17, 1534. [Google Scholar] [CrossRef] [PubMed]
- Bonilla-Gameros, L.; Chevallier, P.; Sarkissian, A.; Mantovani, D. Silver-based antibacterial strategies for healthcare-associated infections: Processes, challenges, and regulations. An integrated review. Nanomed. Nanotechnol. Biol. Med. 2020, 24, 102142. [Google Scholar] [CrossRef] [PubMed]
- Niu, X.; Sun, L.; Zhang, X.; Sun, Y.; Wang, J. Fabrication and antibacterial properties of cefuroxime-loaded TiO2 nanotubes. Appl. Microbiol. Biotechnol. 2020, 104, 2947–2955. [Google Scholar] [CrossRef] [PubMed]
- Cho, J.-W.; Kim, J.; Cho, W.-T.; Kent, W.T.; Kim, H.-J.; Oh, J.-K. Antibiotic coated hinged threaded rods in the treatment of infected nonunions and intramedullary long bone infections. Injury 2018, 49, 1912–1921. [Google Scholar] [CrossRef]
- Liao, C.; Li, Y.; Tjong, S.C. Bactericidal and Cytotoxic Properties of Silver Nanoparticles. Int. J. Mol. Sci. 2019, 20, 449. [Google Scholar] [CrossRef] [Green Version]
- Hernando-Amado, S.; Coque, T.M.; Baquero, F.; Martínez, J.L. Defining and combating antibiotic resistance from One Health and Global Health perspectives. Nat. Microbiol. 2019, 4, 1432–1442. [Google Scholar] [CrossRef]
- Aksel, H.; Mahjour, F.; Bosaid, F.; Calamak, S.; Azim, A.A. Antimicrobial Activity and Biocompatibility of Antibiotic-Loaded Chitosan Hydrogels as a Potential Scaffold in Regenerative Endodontic Treatment. J. Endod. 2020, 46, 1867–1875. [Google Scholar] [CrossRef] [PubMed]
- Jeong, W.-S.; Kwon, J.-S.; Lee, J.-H.; Uhm, S.-H.; Choi, E.H.; Kim, K.-M. Bacterial attachment on titanium surfaces is dependent on topography and chemical changes induced by nonthermal atmospheric pressure plasma. Biomed. Mater. 2017, 12, 045015. [Google Scholar] [CrossRef] [PubMed]
- Valle, J.; Burgui, S.; Langheinrich, D.; Gil, C.; Solano, C.; Toledo-Arana, A.; Helbig, R.; Lasagni, A.; Lasa, I. Evaluation of Surface Microtopography Engineered by Direct Laser Interference for Bacterial Anti-Biofouling. Macromol. Biosci. 2015, 15, 1060–1069. [Google Scholar] [CrossRef] [PubMed] [Green Version]
- Wang, L.; Chen, W.; Terentjev, E. Effect of micro-patterning on bacterial adhesion on polyethylene terephthalate surface. J. Biomater. Appl. 2015, 29, 1351–1362. [Google Scholar] [CrossRef] [PubMed]
- Yang, M.; Ding, Y.; Ge, X.; Leng, Y. Control of bacterial adhesion and growth on honeycomb-like patterned surfaces. Colloids Surf. B Biointerfaces 2015, 135, 549–555. [Google Scholar] [CrossRef] [PubMed]
- Ge, X.; Leng, Y.; Lu, X.; Ren, F.; Wang, K.; Ding, Y.; Yang, M. Bacterial responses to periodic micropillar array. J. Biomed. Mater. Res. Part A 2015, 103, 384–396. [Google Scholar] [CrossRef]
- Mitik-Dineva, N.; Wang, J.; Truong, V.K.; Stoddart, P.R.; Alexander, M.R.; Albutt, D.J.; Fluke, C.; Crawford, R.J.; Ivanova, E.P. Bacterial attachment on optical fibre surfaces. Biofouling 2010, 26, 461–471. [Google Scholar] [CrossRef]
- Lee, J.; Pascall, M.A. Effect of micro—Pattern topography on the attachment and survival of foodborne microorganisms on food contact surfaces. J. Food Saf. 2017, 38, e12379. [Google Scholar] [CrossRef] [Green Version]
- Vasudevan, R.; Kennedy, A.J.; Merritt, M.; Crocker, F.H.; Baney, R.H. Microscale patterned surfaces reduce bacterial fouling-microscopic and theoretical analysis. Colloids Surf. B Biointerfaces 2014, 117, 225–232. [Google Scholar] [CrossRef]
- Jaggessar, A.; Shahali, H.; Mathew, A.; Yarlagadda, P.K.D.V. Bio-mimicking nano and micro-structured surface fabrication for antibacterial properties in medical implants. J. Nanobiotechnol. 2017, 15, 64. [Google Scholar] [CrossRef] [PubMed] [Green Version]
- Chung, K.K.; Schumacher, J.F.; Sampson, E.M.; Burne, R.A.; Antonelli, P.J.; Brennan, A.B. Impact of engineered surface microtopography on biofilm formation of Staphylococcus aureus. Biointerphases 2007, 2, 89–94. [Google Scholar] [CrossRef] [PubMed] [Green Version]
- Dickson, M.N.; Liang, E.I.; Rodriguez, L.A.; Vollereaux, N.; Yee, A.F. Nanopatterned polymer surfaces with bactericidal properties. Biointerphases 2015, 10, 021010. [Google Scholar] [CrossRef] [PubMed] [Green Version]
- Lee, S.W.; Phillips, K.S.; Gu, H.; Kazemzadeh-Narbat, M.; Ren, D. How microbes read the map: Effects of implant topography on bacterial adhesion and biofilm formation. Biomaterials 2020, 268, 120595. [Google Scholar] [CrossRef] [PubMed]
- Jemat, A.; Ghazali, M.J.; Razali, M.; Otsuka, Y. Surface Modifications and Their Effects on Titanium Dental Implants. BioMed Res. Int. 2015, 2015, 791725. [Google Scholar] [CrossRef] [PubMed] [Green Version]
- Li, X.; Qi, M.; Sun, X.; Weir, M.D.; Tay, F.; Oates, T.W.; Dong, B.; Zhou, Y.; Wang, L.; Xu, H.H. Surface treatments on titanium implants via nanostructured ceria for antibacterial and anti-inflammatory capabilities. Acta Biomater. 2019, 94, 627–643. [Google Scholar] [CrossRef] [PubMed]
- Mrad, O.; Saunier, J.; Aymes-Chodur, C.; Rosilio, V.; Bouttier, S.; Agnely, F.; Aubert, P.; Vigneron, J.; Etcheberry, A.; Yagoubi, N. A multiscale approach to assess the complex surface of polyurethane catheters and the effects of a new plasma decontamination treatment on the surface properties. Microsc. Microanal. 2010, 16, 764–778. [Google Scholar] [CrossRef] [PubMed]
- Morata, L.; Cobo, J.; Fernández-Sampedro, M.; Vasco, P.G.; Ruano, E.; Lora-Tamayo, J.; Somolinos, M.S.; Ruano, P.G.; Nieto, A.R.; Arnaiz, A.; et al. Safety and Efficacy of Prolonged Use of Dalbavancin in Bone and Joint Infections. Antimicrob. Agents Chemother. 2019, 63, e02280-18. [Google Scholar] [CrossRef] [PubMed] [Green Version]
- de Oliveira, W.F.; Silva, P.; Silva, R.; Silva, G.; Machado, G.; Coelho, L.; Correia, M. Staphylococcus aureus and Staphylococcus epidermidis infections on implants. J. Hosp. Infect. 2018, 98, 111–117. [Google Scholar] [CrossRef] [PubMed]
- Ortiz, A.D.C.; Fideles, S.O.M.; Pomini, K.T.; Reis, C.H.B.; Bueno, C.R.D.S.; Pereira, E.D.S.B.M.; Rossi, J.D.O.; Novais, P.C.; Pilon, J.P.G.; Junior, G.M.R.; et al. Effects of Therapy with Fibrin Glue combined with Mesenchymal Stem Cells (MSCs) on Bone Regeneration: A Systematic Review. Cells 2021, 10, 2323. [Google Scholar] [CrossRef] [PubMed]
- Wang, Z.; Shen, X.; Yan, Y.; Qian, T.; Wang, J.; Sun, Q.; Jin, C. Facile fabrication of a PDMS @ stearic acid-Al(OH)3 coating on lignocellulose composite with superhydrophobicity and flame retardancy. Appl. Surf. Sci. 2018, 450, 387–395. [Google Scholar] [CrossRef]
- Tuo, Y.; Chen, W.; Zhang, H.; Li, P.; Liu, X. One-step hydrothermal method to fabricate drag reduction superhydrophobic surface on aluminum foil. Appl. Surf. Sci. 2018, 446, 230–235. [Google Scholar] [CrossRef]
- Li, C.; Yang, Y.; Yang, L.; Shi, Z.; Yang, P.; Cheng, G. In Vitro Bioactivity and Biocompatibility of Bio-Inspired Ti-6Al-4V Alloy Surfaces Modified by Combined Laser Micro/Nano Structuring. Molecules 2020, 25, 1494. [Google Scholar] [CrossRef] [PubMed] [Green Version]
- Liu, Y.; Rui, Z.; Cheng, W.; Song, L.; Xu, Y.; Li, R.; Zhang, X. Characterization and evaluation of a femtosecond laser-induced osseointegration and an anti-inflammatory structure generated on a titanium alloy. Regen. Biomater. 2021, 8, rbab006. [Google Scholar] [CrossRef]
- Dumas, V.; Guignandon, A.; Vico, L.; Mauclair, C.; Zapata, X.; Linossier, M.T.; Bouleftour, W.; Granier, J.; Peyroche, S.; Dumas, J.-C.; et al. Femtosecond laser nano/micro patterning of titanium influences mesenchymal stem cell adhesion and commitment. Biomed. Mater. 2015, 10, 055002. [Google Scholar] [CrossRef] [PubMed]
- Long, J.; Pan, L.; Fan, P.; Gong, D.; Jiang, D.; Zhang, H.; Li, L.; Zhong, M. Cassie-State Stability of Metallic Superhydrophobic Surfaces with Various Micro/Nanostructures Produced by a Femtosecond Laser. Langmuir 2016, 32, 1065–1072. [Google Scholar] [CrossRef] [PubMed]
- Pingle, H.; Wang, P.; Thissen, H.; Kingshott, P. Controlled Attachment of Pseudomonas aeruginosa with Binary Colloidal Crystal—Based Topographies. Small 2018, 14, e1703574. [Google Scholar] [CrossRef]
- Wang, Y.; Domingues, J.F.D.S.; Subbiahdoss, G.; van der Mei, H.C.; Busscher, H.J.; Libera, M. Conditions of lateral surface confinement that promote tissue-cell integration and inhibit biofilm growth. Biomaterials 2014, 35, 5446–5452. [Google Scholar] [CrossRef] [PubMed]
- Visai, L.; De Nardo, L.; Punta, C.; Melone, L.; Cigada, A.; Imbriani, M.; Arciola, C.R. Titanium oxide antibacterial surfaces in biomedical devices. Int. J. Artif. Organs 2011, 34, 929–946. [Google Scholar] [CrossRef]
- Zhao, Q.-M.; Sun, Y.-Y.; Wu, C.-S.; Yang, J.; Bao, G.-F.; Cui, Z.-M. Enhanced osteogenic activity and antibacterial ability of manganese–titanium dioxide microporous coating on titanium surfaces. Nanotoxicology 2020, 14, 289–309. [Google Scholar] [CrossRef]
- Souza, J.C.M.; Sordi, M.B.; Kanazawa, M.; Ravindran, S.; Henriques, B.; Silva, F.S.; Aparicio, C.; Cooper, L.F. Nano-scale modification of titanium implant surfaces to enhance osseointegration. Acta Biomater. 2019, 94, 112–131. [Google Scholar] [CrossRef]
- Bharadwaz, A.; Jayasuriya, A.C. Recent trends in the application of widely used natural and synthetic polymer nanocomposites in bone tissue regeneration. Mater. Sci. Eng. C 2020, 110, 110698. [Google Scholar] [CrossRef] [PubMed]
- Spriano, S.; Chandra, V.S.; Cochis, A.; Uberti, F.; Rimondini, L.; Bertone, E.; Vitale, A.; Scolaro, C.; Ferrari, M.; Cirisano, F.; et al. How do wettability, zeta potential and hydroxylation degree affect the biological response of biomaterials? Mater. Sci. Eng. C 2017, 74, 542–555. [Google Scholar] [CrossRef] [PubMed]
- Dickinson, L.E.; Rand, D.R.; Tsao, J.; Eberle, W.; Gerecht, S. Data associated with: Endothelial cell responses to micropillar substrates of varying dimensions and stiffness. J. Biomed. Mater. Res. Part A 2012, 100, 1457–1466. [Google Scholar] [CrossRef] [PubMed] [Green Version]
- Ochsner, M.; Textor, M.; Vogel, V.; Smith, M.L. Dimensionality controls cytoskeleton assembly and metabolism of fibroblast cells in response to rigidity and shape. PLoS ONE 2010, 5, e9445. [Google Scholar] [CrossRef] [PubMed] [Green Version]

| Substrates | Surface Wettability (Water Contact Angle/°) |
|---|---|
| a | 79.5° |
| b | 141.6° |
| c | 78.7° |
| d | 76.2° |
| e | 78° |
Publisher’s Note: MDPI stays neutral with regard to jurisdictional claims in published maps and institutional affiliations. |
© 2022 by the authors. Licensee MDPI, Basel, Switzerland. This article is an open access article distributed under the terms and conditions of the Creative Commons Attribution (CC BY) license (https://creativecommons.org/licenses/by/4.0/).
Share and Cite
Wu, X.; Ao, H.; He, Z.; Wang, Q.; Peng, Z. Surface Modification of Titanium by Femtosecond Laser in Reducing Bacterial Colonization. Coatings 2022, 12, 414. https://doi.org/10.3390/coatings12030414
Wu X, Ao H, He Z, Wang Q, Peng Z. Surface Modification of Titanium by Femtosecond Laser in Reducing Bacterial Colonization. Coatings. 2022; 12(3):414. https://doi.org/10.3390/coatings12030414
Chicago/Turabian StyleWu, Xinhui, Haiyong Ao, Zhaoru He, Qun Wang, and Zhaoxiang Peng. 2022. "Surface Modification of Titanium by Femtosecond Laser in Reducing Bacterial Colonization" Coatings 12, no. 3: 414. https://doi.org/10.3390/coatings12030414
APA StyleWu, X., Ao, H., He, Z., Wang, Q., & Peng, Z. (2022). Surface Modification of Titanium by Femtosecond Laser in Reducing Bacterial Colonization. Coatings, 12(3), 414. https://doi.org/10.3390/coatings12030414






